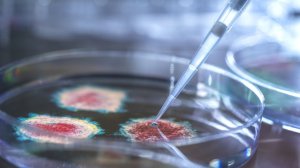
Глава комиссии Lancet Сакс признал, что коронавирус создали в лаборатории

отметили
18
человек
в архиве
отметили
28
человек
в архиве
отметили
28
человек
в архиве
отметили
32
человека
в архиве
Обе нитки «Северного потока» остановят на плановый ремонт с 11 по 21 июля
 iz.ru
iz.ru
Из-за проведения ежегодного планового ремонта обе нитки «Северного потока» остановят в период с 11 по 21 июля. Об этом говорится 1 июля на сайте Nord Stream AG.«С 11 по 21 июля 2022 года компания Nord Stream AG произведет временный останов обеих ниток газопровода «Северный поток» для проведения плановых профилактических работ, включая тестирование механических компонентов и систем автоматизации, д... показать видео
отметили
41
человек
в архиве
[90°] Утратившая связь с реальностью G7 уступает глобальное лидерство БРИКС. «Глобальный Юг» станет основой миропорядка альтернативного Западному, развернув многовековую доминанту силовых полей на 90°
2 inosmi.ru
inosmi.ru
«Большая семерка» не желает делать шагов навстречу Глобальному Югу и интегрировать в свое сообщество развивающиеся страны, пишет The Hill. По мнению автора статьи, при таком подходе западная коалиция может уступить лидерство группе БРИКС, и вскоре ей придется противостоять шести миллиардам человек и...
проблема (1)
отметили
11
человек
в архиве
Кабмин предложил спецмеры для экономики во время операций за рубежом. Какие полномочия получат власти в случае принятия закона
 rbc.ru
rbc.ru
Правительство внесло в Госдуму законопроект, которым предлагает предоставить ему право принять решение о введении специальных мер в сфере экономики. Документ размещен в базе данных нижней палаты парламента.
Законопроект предлагает предоставить правительству полномочия, которые позволят оперативно удовлетворить потребности армии и других воинских формирований в ремонте вооружения и военной...
проблема (7)
отметили
29
человек
в архиве
В Швеции заявили о "неприятном сюрпризе" от Эрдогана для НАТО
 ria.ru
ria.ru
МОСКВА, 2 июл – РИА Новости. Заявление президента Турции Тайипа Эрдогана о получении гарантий от Стокгольма по экстрадиции 73 членов запрещенной в стране Рабочей партии Курдистана (РПК) стало «неприятным сюрпризом» для Швеции, Финляндии и НАТО, такое мнение выразил журналист шведской SVT Хенрик Сильвер.Финляндия, Швеция и Турция 28 июня подписали меморандум в области безопасности. Страны договори...
отметили
25
человек
в архиве
Reuters сообщает о серьезных проблемах в работе энергокомпаний США
 1prime.ru
1prime.ru
На фоне неблагоприятных погодных условий и нехватки оборудования американские энергетические компании сталкиваются с серьезными проблемами, которые могут повлиять на энергоснабжение страны во время жары и ураганов, сообщает Reuters.Энергокомпании предупреждают об испытываемых ими сложностях с поставками оборудования, которые способны подорвать усилия по восстановлению энергоснабжения после перебое...
отметили
11
человек
в архиве
Две авиакомпании попросили разрешения вернуть часть самолетов в иностранный лизинг
 kommersant.ru
kommersant.ru
Авиакомпании AirBridgeCargo и S7 обратились в Минтранс за разрешением вернуть часть самолетов иностранным лизингодателям. Об этом «Ъ» рассказал источник, близкий к Минтрансу.Источник в AirBridgeCargo сообщил, что компания хочет эксплуатировать самолеты совместно с эмиратской Etihad и поэтому просит вернуть в иностранный лизинг 14 из 16 грузовых Boeing 747. Для совместного обслуживания российскую к...
проблема (5)
отметили
20
человек
в архиве
Источник: украинских диверсантов уничтожают с помощью минометов "Галл"
 ria.ru
ria.ru
Российский спецназ уничтожает украинских диверсантов бесшумными минометами 2Б25 «Галл»Российские спецназ применяет в ходе спецоперации бесшумные минометы «Галл», в частности для уничтожения украинских диверсионно-разведывательных групп, сообщил РИА Новости информированный источник. «Спецназ ВС РФ применяет на Украине уникальные бесшумные минометы 2Б25 „Галл“, у которых резко снижены демаскирующие ...
отметили
27
человек
в архиве
Литва назвала «поражением» позицию ЕС по транзиту грузов в Калининград Der Spiegel: в Литве заявили о «поражении» ЕС из-за запрета транзита грузов в Калининград
 iz.ru
iz.ru
Еврокомиссия (ЕК) планирует опубликовать так называемое разъяснение по ситуации с транзитом в Калининград, основная идея которого в том, чтобы позволить его для всех грузов, но в ограниченном объеме, сообщил Der Spiegel в четверг, 30 июня.«Это положит конец спору, который не только привел к резким обвинениям между Россией и Евросоюзом (ЕС), но и выявил глубокие конфликты внутри ЕС по поводу отноше...
отметили
2
человека
в архиве
В семье как в бизнесе. Как партнерский бизнес помогает отношениям и решает финансовые проблемы
 ural.ru
ural.ru
Основной причиной ссор в большинстве семей являются деньги. Из-за финансовой нестабильности ссорятся до 40% пар. Как семейный бизнес решает денежные вопросы и формирует новые модели домашнего поведения, рассказывает президент RC Group Елена Мищенко.Елена, у вас за плечами огромный опыт в предпринимательстве, несколько пережитых кризисов. Как вы оцениваете влияние финансовой ситуации на отношения в...
проблема (5)
отметили
36
человек
в архиве
Глава комиссии Lancet Сакс признал, что коронавирус создали в лаборатории
 russian.rt.com
russian.rt.com
Профессор Колумбийского университета Джеффри Сакс, председатель комиссии по коронавирусу медицинского журнала The Lancet, признал, что вирус создали в лаборатории. Об этом сообщил проект Truth Over News газеты The Epoch Times.Отмечается, что Сакс сделал заявление на конференции в Испании, на которую...
проблема (2)
отметили
16
человек
в архиве
отметили
37
человек
в архиве
Российский разработчик «железа» запустит производство чипов совместно с китайцами
 cnews.ru
cnews.ru
Российский разработчик вычислительной техники Kraftway договорился с китайской компанией YMTC о совместном производстве контроллеров памяти в 2023 г. За два-три года Kraftway планирует выйти на объем производства в 1 млн твердотельных дисков в год. Основными заказчиками станут российские госструктуры, уверены представители отрасли.Грандиозные планыРоссийский производитель компьютерного оборудован...
отметили
30
человек
в архиве
Экс-босс Формулы-1 Экклстоун: по-прежнему готов заслонить Путина от пули
 championat.com
championat.com
Бывший руководитель Формулы-1 Берни Экклстоун выразил поддержку президенту РФ Владимиру Путину и раскритиковал президента Украины Владимира Зеленского.
«Я по-прежнему готов принять пулю за Владимира Путина. Он первоклассный человек. Он посчитал свои действия правильными и считал, что сделает лучше для России. К сожалению, он, как и многие другие деловые люди, время от времени совершает ош...
отметили
34
человека
в архиве
Financial Times: Путин одним указом "щелкнул по носу" Запад и Британию
 ria.ru
ria.ru
МОСКВА, 1 июл — РИА Новости. Президент России Владимир Путин решением о специальных экономических мерах в отношении месторождений «Сахалина-2» проучил западных энергетических гигантов, пишет Financial Times.Накануне глава российского государства подписал указ, согласно которому оператор проекта — Sakhalin Energy (совместное предприятие «Газпрома», Shell, Mitsui и Mitsubishi) — будет заменен на н...
отметили
27
человек
в архиве
[Кандидаты в НАТО]Свастика была символом ВВС Финляндии до 2020 года
 ren.tv
ren.tv
Свастика была символом Военно-воздушных сил Финляндии до 2020 года. ВВС Финляндии использовали свастику на своем флаге и эмблемах с 1918 по 2020 год.В 1945 году тесно связанная с нацистской Германией свастика перестала быть опознавательным знаком финских ВВС — свастику финны убрали с военных самолетов, но оставили на флагах и эмблемах. В Финляндии решили избавиться от свастики только два года наза...
отметили
27
человек
в архиве
Эксперт оценил открытие «Роснефтью» нового месторождения
 iz.ru
iz.ru
Открытие «Роснефтью» на шельфе Печорского моря крупного месторождения говорит о том, что данный регион является «практически нетронутой кладовой углеводородного сырья», отметил заместитель гендиректора Института национальной энергетики Александр Фролов.По его словам, «реализация таких проектов будет способствовать развитию ближайших регионов, а также Северного морского пути».Фролов, эксперт информ...
отметили
30
человек
в архиве
У «Яндекса» появилась нейросеть-полиглот, распознающая десять языков одновременно
 3dnews.ru
3dnews.ru
Облачное подразделение компании «Яндекс» (Yandex Cloud) сообщило о разработке новой системы на базе машинного обучения, которая способна распознавать более 10 иностранных языков одновременно.В основе модели лежат сервис синтеза и распознавания Yandex SpeechKit и специализированная архитектура под названием Transformer. Алгоритмы обрабатывают входные слова параллельно и независимо друг от друга, бл...
отметили
22
человека
в архиве
СМИ: вратаря сборной России Федотова задержали сотрудники военкомата
 topnews.ru
topnews.ru
Ему светит до двух лет лишения свободы.В Санкт-Петербурге оперативники провели задержание вратаря клуба НХЛ “Филадельфия Флайерз” и сборной России Ивана Федотова.После задержания на выходе из ледовой арены в Купчино его тут же отправили в военный комиссариат.Сам спортсмен сопротивления оказывать не стал.Издание “Фонтанка”, Федотова буквально караулили несколько часов сразу в нескольких точка Санкт...
отметили
21
человек
в архиве
отметили
27
человек
в архиве
отметили
2
человека
в архиве
В Казани сотрудники ЛРР Росгвардии рассказали журналистам о вступивших в силу основных изменениях в законе «Об оружии» avalanches.com
На состоявшейся в информационном агентстве «Татар-информ» пресс-конференции начальник отдела контроля за оборотом оружия Центра лицензионно-разрешительной работы Управления Росгвардии по Республике Татарстан майор полиции Рамиль Камалиев рассказал представителям СМИ об основных изменениях в Федераль...
проблема (7)
отметили
7
человек
в архиве
«Грандиозные» планы НАТО слишком опрометчивы
 cont.ws
cont.ws
В новой Стратегической концепции, которую Североатлантический альянс принял на саммите в Мадриде, Россия названа «главной угрозой». То есть врагом №1, который оправдывает существование НАТО, привлечение новых членов и вливание денег в военные расходы, теперь официально является Москва.В последний ра...
отметили
32
человека
в архиве
отметили
37
человек
в архиве
"Лаборатория Касперского" обнаружила вирус, шпионивший за госорганами
 ria.ru
ria.ru
МОСКВА, 1 июл — РИА Новости. «Лаборатория Касперского» обнаружила вирус SessionManager, открывавший доступ злоумышленникам к корпоративной IT-инфраструктуре государственных органов и некоммерческих организаций в Африке, Южной Азии, Европе и на Ближнем Востоке, а также в России, сообщает пресс-служба компании.«Эксперты „Лаборатории Касперского“ обнаружили сложно детектируемый бэкдор (вредоносная п...
отметили
3
человека
в архиве
В Казани росгвардейцы задержали пьяного водителя грузовика, разбившего шесть припаркованных автомашин avalanches.com
В Казани мобильный наряд вневедомственной охраны Росгвардии по срабатыванию тревожной сигнализации задержал ранее судимого гражданина, в нетрезвом состоянии управлявшего грузовиком и подозреваемого в совершении ДТП с участием нескольких автомашин на территории гаражного кооператива.В дневное время э...
проблема (5)
отметили
29
человек
в архиве
Британский магазин ASOS поиздевался над россиянами из-за санкций
 ria.ru
ria.ru
МОСКВА, 1 июл — РИА Новости. Британский онлайн-магазин одежды и косметики ASOS обновил свое приложение в App Store и оставил «послание» российским пользователям.В разделе «Что нового», где разработчики публикуют описание изменений в версиях программы, появился текст «Привет! С сегодняшнего дня мы будем показывать тебе только те товары, которые доступны в твоей стране. Обидно видеть то, что не м...
проблема (2)
отметили
9
человек
в архиве
Что значат слова Путина об американцах, работающих на ядерных объектах в России?
 tjournal.ru
tjournal.ru
Слова президента России Владимира Путина, озвученные 21.12.2021 о том, что в начале 90-ых годов «на объектах ядерного оружейного комплекса РФ сидели на постоянной основе американские специалисты» как-то обошли внимание общество. Хотя в них существовал большой посыл, который до сих пор не был проанал...
проблема (4)








![[90°] Утратившая связь с реальностью G7 уступает глобальное лидерство БРИКС. «Глобальный Юг» станет основой миропорядка альтернативного Западному, развернув многовековую доминанту силовых полей на 90°](/story_images/648000/1656746338_94_375px-Compass_Rose_Russian_North.svg.png)

![[Кандидаты в НАТО]Свастика была символом ВВС Финляндии до 2020 года](/story_images/648000/1656699819_55_7736db696d7dcdf65626dd59f39c5402ee3d50d3.jpg)





